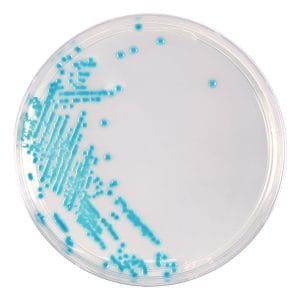
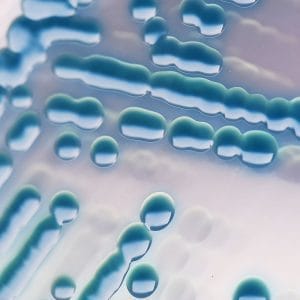
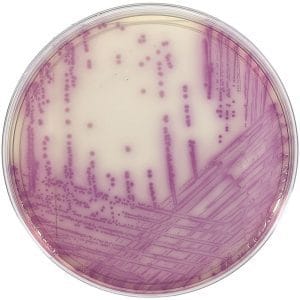

Description
Specifications
- ModelNano-500
- Wavelength range200-800 nm
- Minimum sample size0.5-2.0 μl
- Path length0.05 mm, 0.2 mm, 1.0 mm
- Light sourceXenon flash lamp
- Detector type2048-Linear CCD array
- Wavelength accuracy1 nm
- Spectral resolution≤3 nm
- Absorbance precision0.003Abs
- Absorbance accuracy1 % (7.332Abs at 260 nm)
- Absorbance range0.04 – 300A
- Detects nucleic acid up to2-15000 ng/μl (dsDNA)
- Measurement time<6 S
- Data outputUSB
- Sample pedestal materiaAluminum alloy and Quartz fiber
- Operating voltageDC 24 V 2 A
- Operating power25 W
- Standby power5 W
- Dimension (WxDxH)mm208×320×186
- Weight3.6kg
- Software compatibilityAndroid system
- OD600nm measurement
- Light sourceLED
- Wavelength range600±8 nm
- Absorbance range0-4 A
- Fluorescent detection
- SensitivitydsDNA:0.5 pg/μl
- Linear dynamic rangeR²≥0.995
- Repeatability≤1.5 %